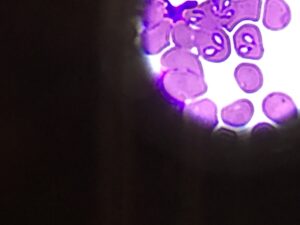
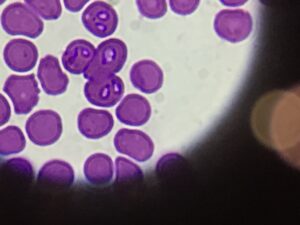

Babesioza u psów
Babeszjoza – groźna choroba wywoływana przez pierwotniaki z rodzaju Babesidae, u psów głównie przez Babesia canis oraz Babesia gibsoni, charakteryzuje się gorączką, depresją, niedokrwistością, zażółceniem błon śluzowych, zaburzeniami ze strony układu krążeniowego, nerwowego oraz przewodu pokarmowego.
babesioza u psów
Nosicielami są kleszcze z rodzaju Dermacentor pictus, D. marginatus, Rhipicephalus sanquineus i Rh. turanicus , zarówno stadia larwalne, jak i postaci dorosłe kleszcza – imago.
*Do zarażenia pierwotniakami Babesia może dochodzić także na skutek kontaktu ran z zainfekowaną
krwią. Sytuacje takie miały często miejsce podczas walk psów. Dojść do zainfekowania może poprzez
przetoczenie krwi. Pierwotniaka może przekazać również ciężarna suka swoim szczeniętom.
Charakterystyka patogenu. Babesia canis ma wielkość około 4–5 µm, Babesia gibsoni jest znacznie mniejsza – 1–2,5 µm. W trakcie pobierania krwi przez kleszcze do organizmu psa zostają
wprowadzone sporozoity, które przekształcają się w trofozoity, a następnie w obrębie krwinek czerwonych ulegają podziałom na dwa gruszkowate merozoity. Z czasem doprowadzają one do destrukcji erytrocytów, co klinicznie objawia się anemią. W jednym erytrocycie znajduje się od 1 – 2 do 8, a nawet do 16 – 32 patogenów. Zakażenie erytrocytów sięga 5-10%.
Dane epizootologiczne. Babesia canis występuje w Europie, Afryce, Azji, Ameryce. Zwierzęta chorują w każdym wieku, ale osobniki młode są bardziej podatne na zarażenie, u nich przebieg choroby z reguły najcięższy. Zwierzęta chorują głównie wiosną i jesienią, wiąże się to z sezonową aktywnością kleszczy. Jednak, co raz częściej do zachorowania dochodzi też w miesiącach letnich lub nawet zimowych, wystarczy, że temperatura gleby przekracza +5 – +7 stopni Celsjusza.
Patogeneza. Intensywne rozmnażanie pierwotniaków wewnątrz krwinki czerwonej oraz toksyczne produkty ich aktywności życiowej powodują postępującą hemolizę erytrocytów, co prowadzi do
anemii. Procesy dystroficzne i zapalne rozwijają się w wątrobie, trzustce, nerkach. Zaburza się wodno- elektrolitowy balans oraz równowaga kwasowo-zasadowa w organizmie. W surowicy krwi psów chorych na babeszjozę znacznie wzrasta zawartość mocznika, kreatyniny, bilirubiny, aktywność amylazy, co potwierdza obecność ostrych procesów zapalnych w trzustce, wątrobie, nerkach oraz rozwoju ostrej niewydolności nerek.
Objawy choroby . Okres inkubacji trwa 1 – 2, czasem do 3 tygodni. Przebieg choroby jest ostry, rzadziej podostry, przewlekły i nietypowy.
- Przebieg ostry charakteryzuje się gwałtowną depresja i utrata apetytu. Temperatura ciała wzrasta do 41 – 42 ° C, rozwija się tachykardia. Pojawia się przyspieszenie oddechów. Błony śluzowe są początkowo blade, później rozwija się żółtaczka. Często obserwuje się zwiększone pragnienie, biegunka i wymioty. Występuje osłabienie kończyn, zwłaszcza miednicznych, może wystąpić niedowład. Mocz staje się czerwony lub ciemnobrązowy. Palpacja ujawnia wzrost i bolesność wątroby, śledziony, nerek. Zawartość hemoglobiny, liczba erytrocytów i wskaźnik hematokrytu gwałtownie spadają. Choroba trwa od 3 do 9 dni i bez szybkiego wdrążenia odpowiedniej terapii często kończy się śmiercią.
- Przebieg podostry charakteryzuje się zmniejszeniem apetytu, obserwuje się wzrost temperatury ciała do 40 – 40,5 ° C, depresję, brakiem aktywności fizycznej, czasami hemoglobinurię. Żółtaczka błon śluzowych jest mniej wyraźna. Choroba trwa od 2 do 3 tygodni i może być śmiertelna.
- W przebiegu przewlekłym objawy babeszjozy są słabo wyrażone. Temperatura ciała wzrasta do 40 ° C w pierwszych dniach choroby, a następnie normalizuje się. Psy są przygnębione, zmniejsza się apetyt. Choroba trwa od 3 do 6 tygodni i kończy się przeważnie powolnym powrotem do zdrowia. Najbardziej uporczywymi objawami o przebiegu podostrym i przewlekłym są niedokrwistość i kacheksja.
Ostatnio zaobserwowano nietypowy przebieg choroby. W tym przypadku temperatura ciała pozostaje w normie fizjologicznej. Obserwuje się depresja, osłabienie, zmniejszenie apetytu, może
wystąpić zaostrzenie przewlekłego zapalenia wątroby jak również zapalenia trzustki. Błony śluzowe
są blade, a w przypadku niewydolności krążeniowo-oddechowej występuje sinica. Mocz ma kolor żółty.
Diagnostyka . W celu wykrycia Babesii badane są rozmazy krwi. Krew pobiera się z naczyń włosowatych ( wierzchołek ucha lub końcówka ogona). Przygotowany rozmaz jest następnie suszony i
utrwalany. Utrwalony rozmaz barwiony przy użyciu różnych barwników. Najbardziej rozpowszechnioną metodą barwienia jest metoda Romanovsky – Giemsa. Babesia wyraźnie widoczna na różowym tle erytrocytów w postaci gruszkowatego merozoity mającego niebiesko-fioletową protoplazmie, czasami z wakuoli w środku, i jądra w postaci różnorodnie ukształtowanych wtrąceń
chromatyny rubinowego lub czerwono-fioletowego koloru.
Różnicowanie. Nie należy stawiać diagnozy wyłącznie na podstawie badania rozmazów krwi barwionych metodą Giemsy. Konieczne jest odróżnienie piroplazmozy od leptospirozy, dżumy,
zakaźnego zapalenia wątroby. W leptospirozie, w przeciwieństwie do piroplazmozy, obserwuje się krwiomocz, a w piroplazmozą hemoglobinurię. Zakaźne zapalenie wątroby występuje z ciągłą gorączką, anemią i zażółceniem błon śluzowych, ale kolor moczu z reguły się nie zmienia. Czasami wykonuje się testy serologiczne lub PCR w celu zdiagnozowania piroplazmozy.
Zapobieganie i zwalczanie . Główną metodą profilaktyki babeszjozy u psów jest zapobieganie inwazji kleszczy . W tym celu należy unikać wyprowadzana psów w miejscach o wysokim ryzyku inwazji. Najczęściej kleszcze są spotykane na obrzeżach lasów, łąk, na polanach, błoniach nad stawami i jeziorami oraz w zagajnikach z zaroślami. U zwierząt wrażliwych na chorobę, które czasowo przebywają w miejscach jej endemicznego występowania można stosować chemioprofilaktykę jako metodę zapobiegania chorobie. Jedynym preparatem, który wykazuje stosunkowo długi efekt zabezpieczający zwierzęta przed pierwotniakami jest dipropionian imidokarbu. Jednorazowa iniekcja chroni zwierzęta przed inwazją B. canis przez 2–4 tygodni. Jednak ze względu na jego toksyczny wpływ na wątrobę preparat ten należy używać z dużą ostrożnością. Zaleca się stosowanie produktów zawierających kombinację następujących substancji: Imidaklopryd w połączeniu z flumetryną, sarolaner, fluralaner, afoksolaner. Każdy z tych środków może wywoływać objawy niepożądane ze strony układu pokarmowego, świąd, ospałość lub brak apetytu. Objawy te są zwykle ograniczone i szybko przemijające.
Okresowe badania krwi (minimum raz do roku u zwierząt młodych i zdrowych lub minimum dwa razy do roku u zwierząt starszych lub mających choroby przewlekłe) pomogą kontrolować pracę narządów wewnętrznych i zapobiegać ewentualnemu toksycznemu wpływowi środków przeciw kleszczowych.
Autorzy tekstu
Zespół PROVET
Masz pytania? Zadzwoń do autorów tekstu pod numer 32-228-59-86
Literatura
1. Łukasz Adaszek, Stanisław Winiarczyk Babeszjoza psów – wciąż aktualny problem.
Wiadomoœci Parazytologiczne 2008, 54(2), 109–115
2. Łukasz Adaszek, Stanisław Winiarczyk Szczepienia psów i bydła przeciwko babeszjozie.
Życie Weterynaryjne • 2014 • 89(1)
3. Wodzianow A. A. Morfologia, biologia i diagnostyka laboratoryjna czynników sprawczych
inwazyjnych chorób zwierząt: podręcznik szkoleniowy, 2014, 220